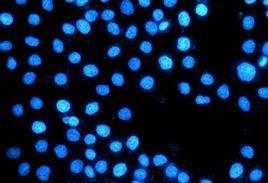
hoechst hoechst

簡介
Hoechst 染料
Hoechst是一類。(’)
hoechst最初由 Hoechst AG公司發明。這是一家德國公司,創建於1863年,後來經過數次合併,變成了Sanofi-Aventis(賽諾菲)集團的子公司。它們所有的試劑都以數字編號命名,也就是說Hoechst 33342是該公司合成的的第33342種化合物。
類似的染料一共有三種:Hoechst 33258, Hoechst 33342, 和 Hoechst 34580。33342和33258最常用,激發/發射光譜也比較接近。
分子特性
三種染料都可在350nm左右的紫外光激發。都在461nm處發出藍靛色螢光。未被結合的染料最大發射光在510到540nm之間。可被氙-氬燈或水銀-氬燈或紫外雷射激發。激發光和發射光之間的斯托克斯位移巨大,故可用於多染料多顏色螢光染色。Hoechst染料的螢光強度隨著溶液pH升高而增強。
Hoechst染料溶於水和有機溶劑,如二甲基甲醯胺或二甲基亞碸。濃度可高達10mg/mL.水溶液可在4 °C避光保存至少6個月。長期儲存於≤-20 °C
Hoechst與DNA雙鏈中的小溝(minor groove)結合,更傾向於富含A/T(腺嘌呤/胸腺嘧啶)的DNA鏈。雖然說它能與所有的核酸結合,但是富含A/T的雙鏈DNA使螢光強度顯著增強。
Hoechst可穿過細胞膜,可結合於活細胞或固定過的細胞。因此可用於活細胞標記
Hoechst能與DNA結合,干擾DNA複製和細胞分裂,因此有致畸和致癌危險。使用和廢棄需謹慎。